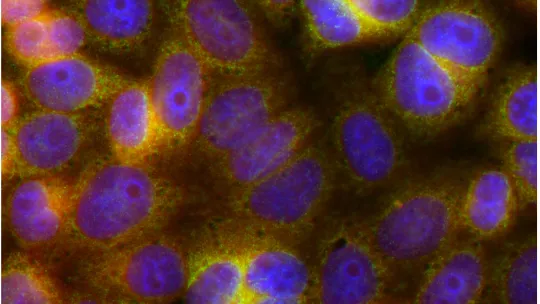
preclinical models

IRB Barcelona has different preclinical disease models, which can be used to validate therapeutic hypothesis.
Disease models that mimic the patient are mandatory to identify and develop the best treatment for a certain pathology. These models can be developed in two ways: (i) by partially “reconstructing” the pathology using samples derived from patients (organoids and xenografts) and, (ii) derived from extensive genetic comprehensive analysis and reproducing the cellular and molecular aspects of the disease through genetic manipulation in a global systemic context of a model organism (i.e. murine models). As an example of the relevance of adapting this type of model to the identification of novel targets and treatments, more than 96% of new cancer treatments developed in simple cellular models fail to be transferred to the patient.
IRB Barcelona has a broad set of preclinical models for different pathologies, from as simple as yeast to highly complex such as immunocompetent rodents.
In-vitro cell-based models:
- 2D In-vitro models – cell lines
- 3D In-vitro models – organoids
- Patient-derived (PDX, cell lines)
In-vivo models:
- Genetic models
- Xenographs (patient derived cells, cell lines)
Species:
Murine, Xenopus, Drosophila, Saccharomyces, Candida
Please contact us to know more about the existence of a specific model.
Contacto

